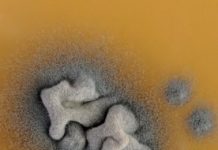
Research: Better understanding of antifungal drug resistance —

Research: Should I stay or should I go? Research sheds light on social drivers...
Why would males and females choose different reproductive strategies? For golden lion tamarins in the Brazilian rain forest, the answer may offer clues...
Research: Thirteen new ant species discovered in Hong Kong —
"If you believe that all life surrounding you in Hong Kong has been discovered, then you'll realise that you just need to look...
Research: Otherworldly mirror pools and mesmerizing landscapes discovered on ocean floor —
While exploring hydrothermal vent and cold seep environments, Dr. Mandy Joye (University of Georgia), and her interdisciplinary research team discovered large venting mineral...
Research: Scientists discover first organism with chlorophyll genes that doesn’t photosynthesize —
For the first time scientists have found an organism that can produce chlorophyll but does not engage in photosynthesis.
The peculiar organism is dubbed...
Research: Better understanding of antifungal drug resistance —
Ground-breaking work by university experts in Tennessee, Texas and Swansea is helping develop a better understanding of the growing threat posed by antifungal...
Research: Effects of reintroducing top predators questioned —
For years, scientists have assumed that when top predators are reintroduced to an ecosystem, the effects are predictable: The ecosystem will return to...
Research: It’s a one-way street for sound waves in this new technology —
Imagine being able to hear people whispering in the next room, while the raucous party in your own room is inaudible to the...
Research: Global warming disrupts recovery of coral reefs —
The damage caused to the Great Barrier Reef by global warming has compromised the capacity of its corals to recover, according to new...
Research: Optical tweezers achieve new feats of capturing atoms —
Trapping single atoms is a bit like herding cats, which makes researchers at the University of Colorado Boulder expert feline wranglers.
In a new...
Research: Structure suggested by theorists decades ago —
Astronomers used the National Science Foundation's Karl G. Jansky Very Large Array (VLA) to make the first direct image of a dusty, doughnut-shaped...
Top News
Hey ISIS, You Suck: Local Muslims Post Anti-ISIS Billboard
A new billboard on Manchester Road in Missouri reads, "HEY ISIS, YOU SUCK!!! From: #ActualMuslims."
A group of Muslim-Americans have put up a blunt billboard...